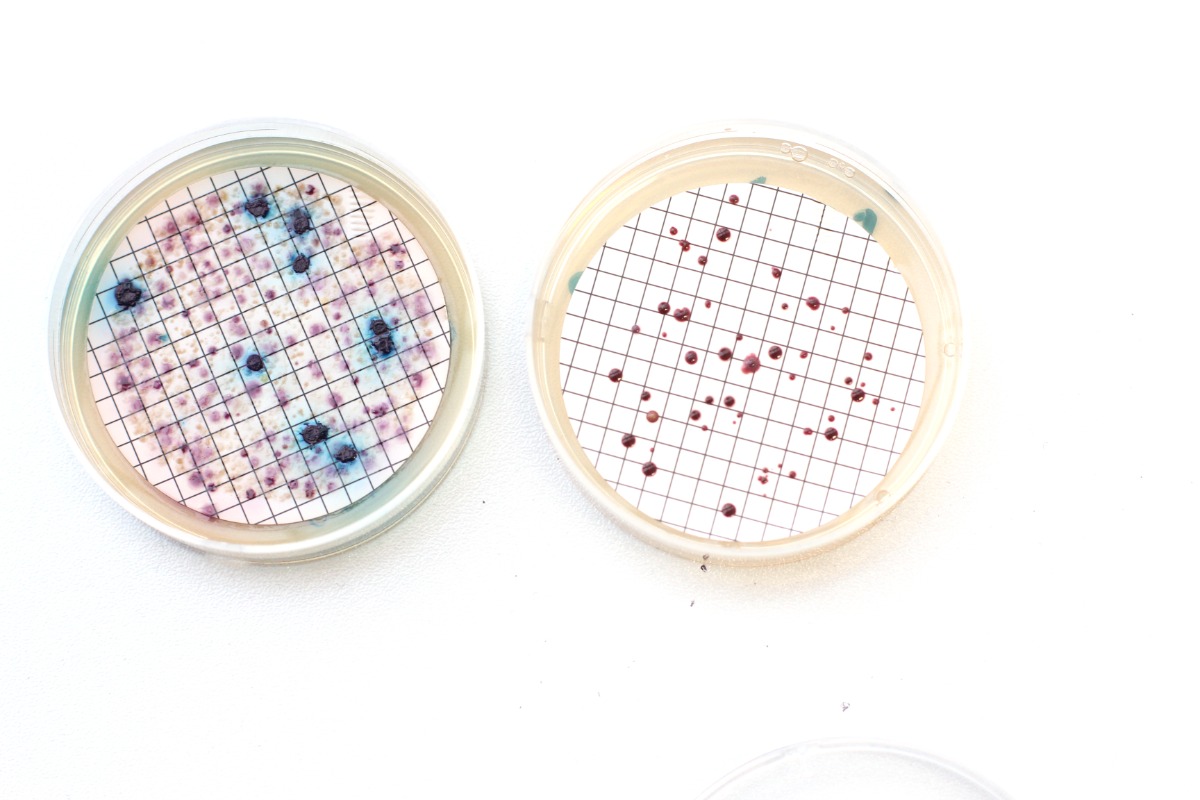
IMG_7626-změněno-na-1200x800.jpeg

Dlouhé dny nejistoty při čekání na výsledky rozboru vody končí. Liberecký Ústav pro nanomateriály, pokročilé technologie a inovace (CXI) Technické univerzity v Liberci přichází s převratnou metodou, která dokáže identifikovat nebezpečné patogeny v řádu hodin. Díky pokročilé genetické analýze qPCR už laboratoře nemusí čekat, až bakterie vyrostou v miskách, ale hledají přímo jejich DNA. Tato inovace, která je unikátní v rámci celé České republiky, znamená zásadní posun v ochraně veřejného zdraví.
Tradiční mikrobiologické rozbory vody se dosud spoléhaly na kultivaci vzorků, což v praxi znamenalo čekání dva až tři dny, než se případné kolonie bakterií v živném roztoku rozrostou. Nová metoda vyvinutá v Liberci tento proces radikálně zrychluje a zpřesňuje. „Výsledky jsme schopni získat už během několika hodin od přivezení vzorku. To umožňuje provozovatelům vodovodních systémů reagovat prakticky okamžitě – například upravit provoz, provést dezinfekci nebo omezit používání vody ještě předtím, než se problém rozšíří,“ vysvětluje Magda Nechanická z CXI TUL, která za vývojem nové metodiky stojí.

Kromě bezprecedentní rychlosti nabízí molekulárně-genetický rozbor i vyšší citlivost. Dokáže totiž odhalit patogeny, jako jsou Legionella nebo E. coli, i v situacích, kdy se skrývají v takzvaných biofilmech – slizovitých vrstvách na stěnách potrubí, které běžné testy často přehlédnou. Tato technologie tak poskytuje mnohem věrnější obraz o skutečném stavu vodovodních systémů, bazénů či teplovodů. Analytická laboratoř CXI je v současnosti jediným pracovištěm v tuzemsku, které má na tuto komplexní sadu analýz oficiální akreditaci.
Inovativní služba je nyní dostupná nejen vodohospodářům a hygienikům, ale i široké veřejnosti. Liberecké pracoviště nabízí možnost nechat si otestovat pitnou, rekreační i teplou vodu pomocí této moderní diagnostiky. „Zájemci si u nás mohou nechat provést jak běžné laboratorní analýzy vody, tak i moderní qPCR analýzu zaměřenou na rychlou detekci patogenů ve vodě nebo v biofilmu,“ doplňuje Lenka Lacinová z Analytické laboratoře CXI TUL. Metoda tak představuje zásadní nástroj pro prevenci epidemií a rychlé řešení havárií.

Úspěšné zavedení této technologie do praxe bylo možné díky podpoře z programu Technologické agentury ČR (TA ČR). Vývoj se od počátku zaměřoval na to, aby vědecký objev nezůstal jen v laboratoři, ale stal se běžně dostupným standardem moderního vodohospodářství. Akreditovaná metoda z Liberce tak nyní otevírá cestu k nové éře monitoringu vody, kde rychlost a přesnost hrají klíčovou roli v bezpečnosti každého kohoutku v zemi.
Zdroj: T-UNI
Technická univerzita v Liberci Ústav pro nanomateriály analýza vody pitná voda